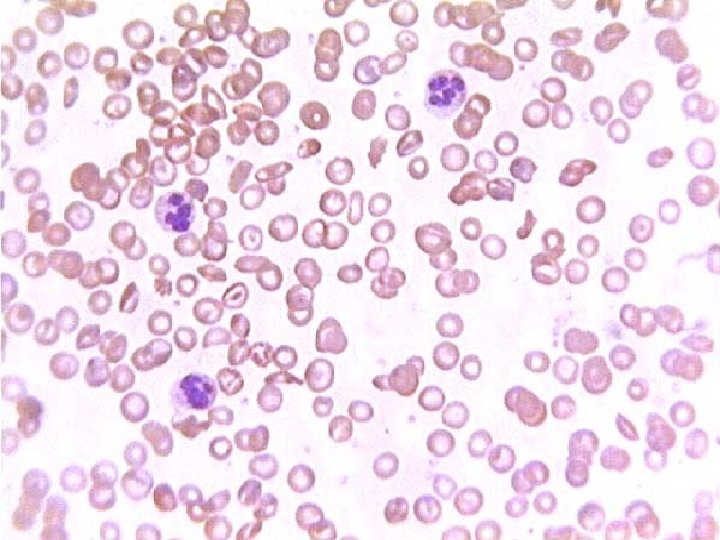

Cell Biology ProkaryoticEukaryotic Structures and Functions Cell Membrane

Cell Biology Prokaryotic/Eukaryotic Structures and Functions Cell Membrane Reproduction (asexual)

History • What is the cell theory? (2 parts) • All organisms are made of cells • The cell is structural and functional unit of every organism. • All cells come from preexisting cells. (division) • Are there any living organisms not made of cells? • No • Viruses (not considered to be living)

Scientists • Robert Hooke (English) is the scientist who first observed cells (cork) under a microscope in 1663. He is responsible for the name cell, meaning small compartment. • Anton van Leeuwenhoek was the first person to observe live cells (protists) under a microscope. • Schwann and Schleiden discovered the nucleus in a plant cell. They were the first to publish the “cell theory”.

First Cell Theory • Cells are the basic unit of organization • The cell retains a dual existence as a distinct entity and a building block in the construction of organisms. • Cells form by free-cell formation, similar to the formation of crystals (spontaneous generation). • Which one of the three is incorrect?

What is a cell? • How do you define a cell? • The smallest structure that retains the basic principals of life: – Survival (acquiring food or making food) – Protection from its environment – Able to reproduce


Bacteria • The simplest of cells are called prokaryotic cells. This includes the kingdom of Bacteria. • Bacteria are the most common organism, able to survive in even the harshest environments. What does a cell need to survive? • Cell Membrane • Genetic material • Ribosomes (protein manufacturing)


Other structures • Cell wall (peptidoglycan) used for structure and support • Flagella used in movement • Cillia used in movement (can also be used to trap food. • Spores some bacteria can form spores under times of environmental stress (low food or toxin) to increase survival rates.

How do we fight bacteria? • Bacteria are tiny organisms, most are less than 1/100 of your smallest cell. How does your body or antibiotics (medicine) target the bacteria when your are sick without killing your normal cells?

Strains of Bacteria • • • What are three types of Bacteria? Cocci (spherical) Bacilli (Rods) Spirilla (curved walls) Streptococci (Chained cocci strand) – Sore throat,




Eukaryotes • Eukaryotes are considered the cell type of all other organisms outside of bacteria. • Eukaryotes make up 4 of the 5 kingdoms (Animal, Plant, Protista, Fungi) • Main differences: – Membrane bound organelles – Nucleus (houses DNA) – Size (anywhere from 10 – 10000 times the size of a bacteria)

Eukaryotes vs Prokaryotes Eukaryotes Prokaryotes • Large, complex cells containing membrane bound organelles • Single cells and complex organisms (4 kingdoms) • Cell wall contains cellulose • Distinct nucleus with a nuclear membrane to contain genetic material • Simple cells, containing only basic structures • Single celled organisms (Kingdom Monera) • Cell Wall consists of peptiodglycan • No nucleus, genetic information in the cytoplasm

Organization • Kingdom – Phylum • Class –Order » Family • Genus • Species

• Organism – Organ System (Respiratory system) • Organ (Lungs) –Tissue (Muscle) » Cell (skin) • Organelle (mitochondria)

Cell Parts • Cell Membrane: Bi-layer of lipids and proteins, serves as the barrier to the cell (semipermiable) • Nucleus: Houses the genetic information (DNA) of the cell. Has a nuclear membrane to separate the nucleus from the cytoplasm • Cytoplasm: Fluid region of the cell that contains all of the cells organelles. Also able to go through chemical processes.






Organelles • Mitochondria: powerhouse of the cell. Responsible for providing energy by breaking down macromolecules. (plant and animal) • Chloroplast: contains chlorophyll (green). Responsible for making sugars and going through photosynthesis. (plants) • Can a cell have more than one of each? • Which cell type would you expect to have more mitochondria?



• Golgi apparatus: membrane bound structure responsible for processing and packaging proteins produced in the endoplasmic reticulum. • Endoplasmic Reticulum: Long membrane bound structure (folded like an intestine track) that is responsible for folding and forming proteins that are being put together by ribosomes (two types: smooth + rough) • Ribosomes (not organelles) responsible for changing the genetic info into protein chains (made of r-RNA)







• Cell Wall: Thick, protective outer layer. Gives cell structure at a loss of mobility. (plant) • Vacuole: variety of purposes, in animals (small) it is used for intercellular digestion, waste removal, defense against invaders; Plants it is used for turgor pressure which keeps the cell shape (large) • Cytoskeleton: provides structure and support for the cell. Involved in cell division as well as cell movement. Consists of proteins called microtubules that attach at central positions called centromeres







Plant Cell vs Animal Cell Plant Cell Animal Cell • Contains cell wall, giving cell more of a box-like shape • Large vacuole that dominates most of the cell’s interior • Contains chloroplasts which give the cell a green color • Structure is based on a cytoskeleton giving the cell a more fluid shape and ability to move • Small vacuoles used in cellular digestion and transport




- Slides: 60